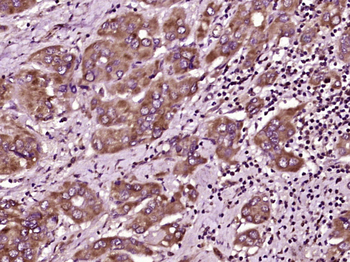
MAL2 Rabbit Polyclonal Antibody

You have no items in your shopping cart.
You have no items in your shopping cart.
| Catalog Number | orb157841 |
|---|---|
| Category | Antibodies |
| Description | MAL2 Rabbit Polyclonal Antibody |
| Target | MAL2 |
| Clonality | Polyclonal |
| Species/Host | Rabbit |
| Isotype | IgG |
| Conjugation | Unconjugated |
| Reactivity | Human |
| Predicted Reactivity | Bovine, Mouse, Porcine, Rat |
| Form/Appearance | Liquid |
| Concentration | 1mg/ml |
| Buffer/Preservatives | 0.01M TBS (pH7.4) with 1% rAlbumin, 0.02% Proclin300 and 50% Glycerol. |
| Purification | Affinity purified by Protein A |
| Immunogen | KLH conjugated synthetic peptide derived from human MAL2 (21-120/176aa) |
| UniProt ID | Q969L2 |
| MW | 19 kDa |
| Tested applications | IF, IHC-Fr, IHC-P |
| Dilution range | IHC-P=1:100-500, IHC-F=1:100-500, IF=1:100-500 |
| Antibody Type | Primary Antibody |
| Storage | Maintain refrigerated at 2-8°C for up to 2 weeks. For long term storage store at -20°C in small aliquots to prevent freeze-thaw cycles. |
| Alternative names | MAL 2; MAL proteolipid protein 2; Mal, T cell diff Read more... |
| Research Area | Cell Biology, Lipid Metabolism |
| Note | For research use only |
| Expiration Date | 12 months from date of receipt. |
Paraformaldehyde-fixed, paraffin embedded (human liver carcinoma), Antigen retrieval by boiling in sodium citrate buffer (pH6.0) for 15 min, Block endogenous peroxidase by 3% hydrogen peroxide for 20 minutes, Blocking buffer (normal goat serum) at 37°C for 30 min, Antibody incubation with (MAL2) Polyclonal Antibody, Unconjugated (orb157841) at 1:400 overnight at 4°C, followed by operating according to SP Kit (Rabbit) instructionsand DAB staining.
IF, IHC-Fr, IHC-P | |
Bovine, Mouse, Porcine, Rat | |
Human | |
Rabbit | |
Polyclonal | |
Biotin |
IF | |
Bovine, Mouse, Porcine, Rat | |
Human | |
Rabbit | |
Polyclonal | |
APC |
IF | |
Bovine, Mouse, Porcine, Rat | |
Human | |
Rabbit | |
Polyclonal | |
PE |
IHC-Fr, IHC-P | |
Bovine, Mouse, Porcine, Rat | |
Human | |
Rabbit | |
Polyclonal | |
HRP |
IF | |
Bovine, Mouse, Porcine, Rat | |
Human | |
Rabbit | |
Polyclonal | |
Cy3 |
Participating in our Biorbyt product reviews program enables you to support fellow scientists by sharing your firsthand experience with our products.
Login to Submit a Review